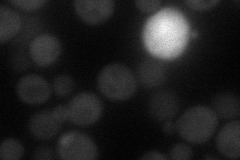
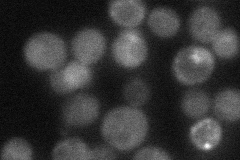
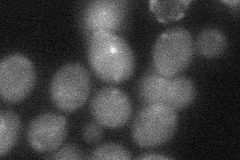
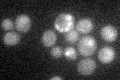

View description
Transcriptional activator involved in the transcription of TPO2, YRO2, and other genes putatively encoding membrane stress proteins; involved in adaptation to weak acid stress
Localization:
Intensity:
Fold change:
Significance:
-
C’ GFP library in SD

cytosol32.1 -
N' NOP1pr-GFP in SD

cytosol39.721 -
N' TEF2pr-mCherry in SD
nucleus37.0942 -
N' NATIVEpr-GFP in SD
cytosol37.2297 -
N' TEF2pr-VC and Cyto-VN in SD
cytosol31.4937 -
C’ GFP library in SD+DTT

cytosol30.680.95No -
C’ GFP library in SD+H2O2

cytosol35.811.11No -
C’ GFP library in Starvation Media
cytosol30.80.95No -
C’ GFP library on the background of Pup2-DaMP

cytosol -
C’ GFP library on the background of CCT mutant

cytosol28.86760.899138No
